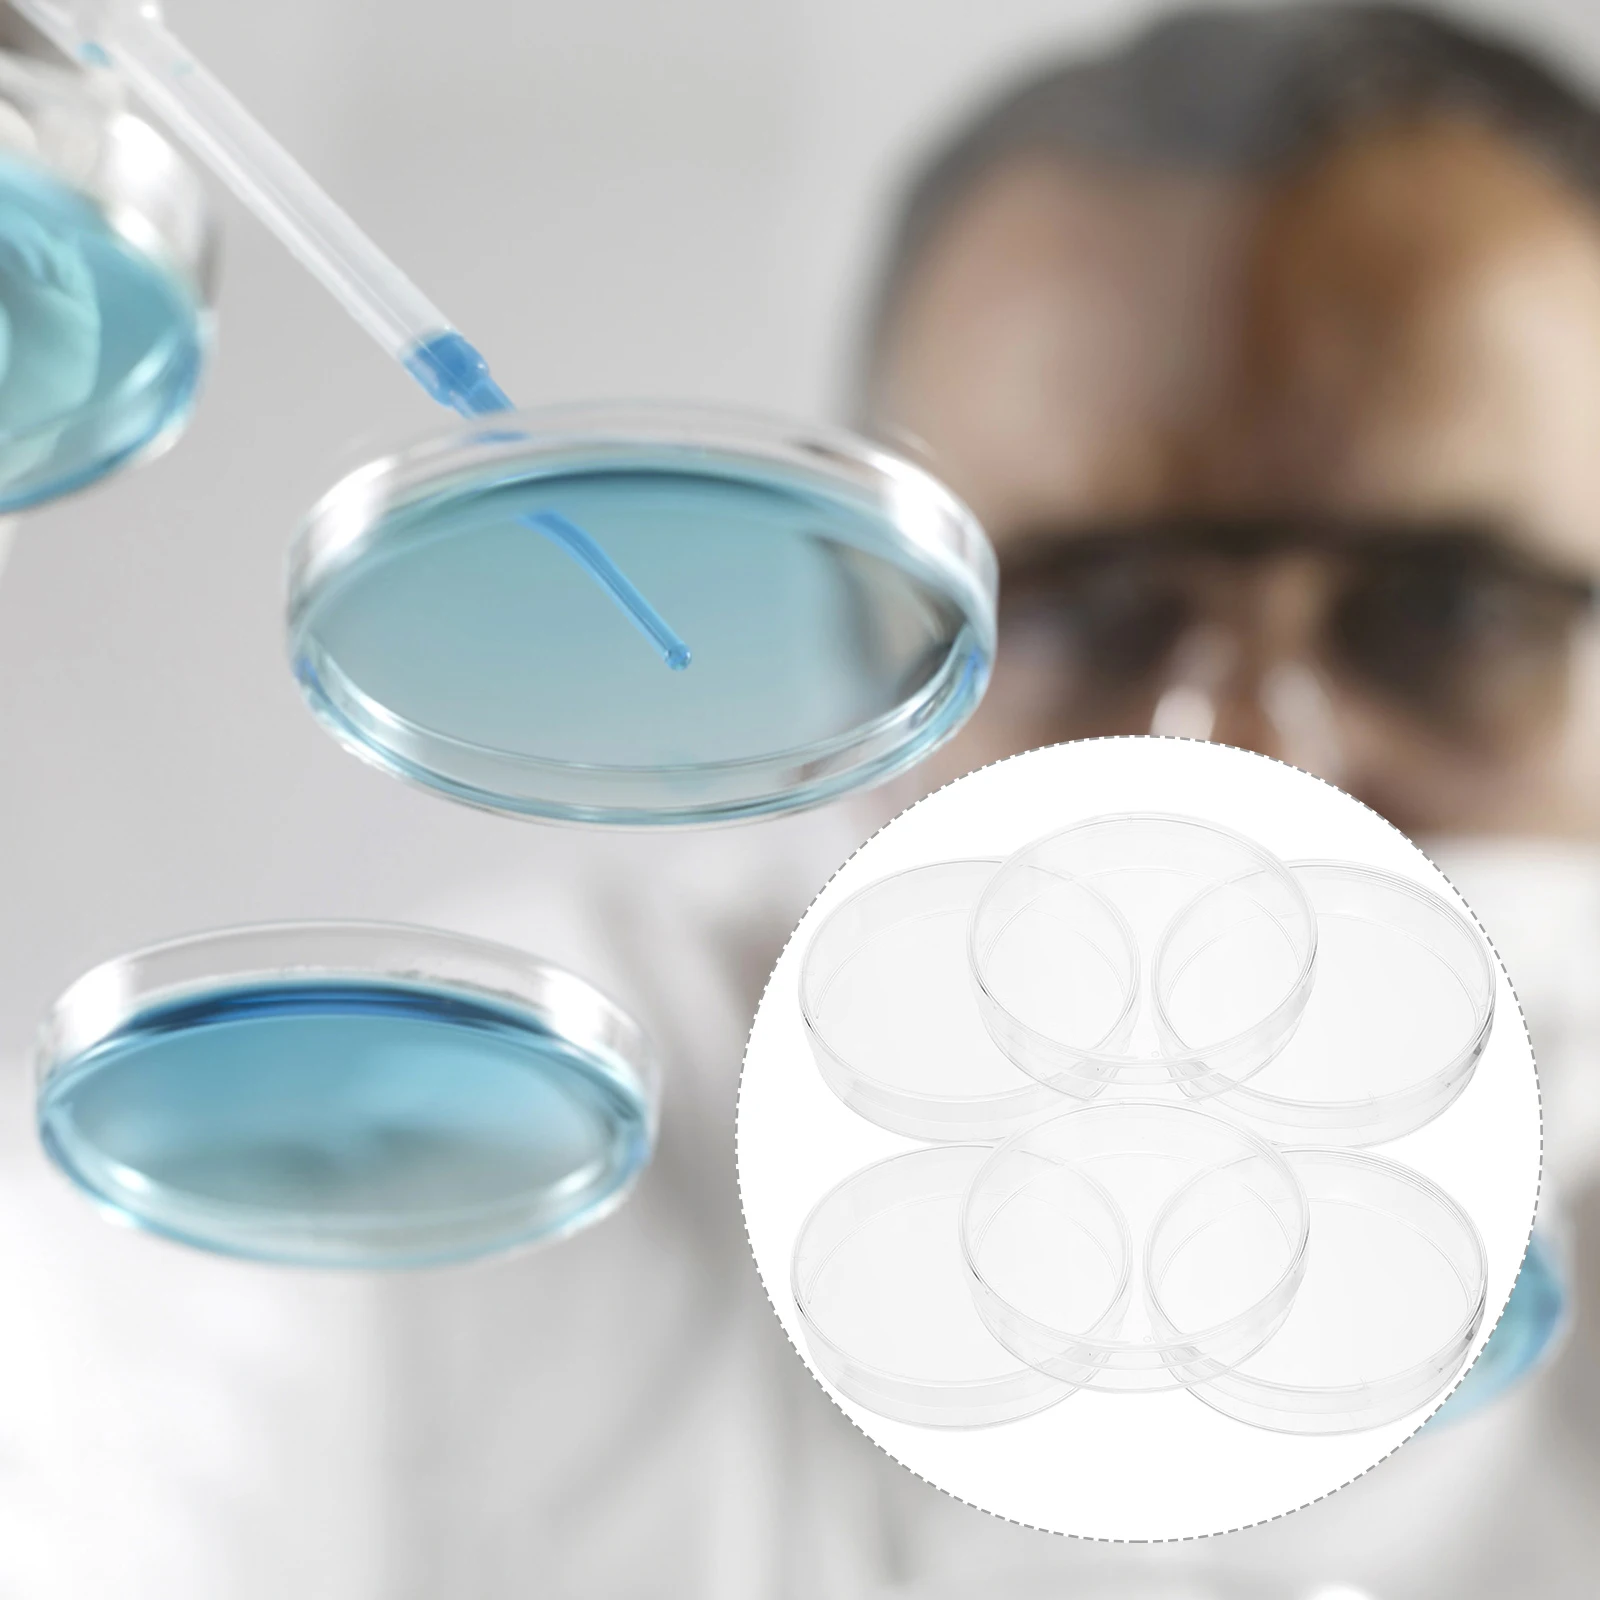
30 Pcs Culture Plate Tissue Equipment Science Experiment Lab Clear Specimen Container Petri Dish for Microscope Iced Supply

Дышащая ротанговая охлаждающая летняя кровать для сна для домашних животных для собак кошек для дома улицы B03E
Price history chart & currency exchange rate
Customers also viewed

354.49 руб.
Детские Топы с длинным рукавом, осенняя новая Базовая рубашка для мальчиков и девочек с мультипликационным принтом, детская модная футболка в Корейском стиле
aliexpress.ru
717.75 руб.
Women Transparent Fishing Net Sexy Body Stocking Fishnet Bodysuit Long Sleeve Crystal Diamonds Rhinestone Bodystocking Lingerie
aliexpress.ru
23,261.10 руб.
Разноцветный настенный светодиодный светильник, RGB, управление через приложение, треугольные игровые светильники, идеальный декор для комнаты, гостиной
aliexpress.ru
318.65 руб.
Стразы цепочка с подвеской-бабочкой ожерелье-чокер цепочки на шею хрустальное ожерелье для тенниса для женщин эффектные хип-хоп очаровательные ювелирные изделия
aliexpress.ru
294.75 руб.
decorative flowers & wreaths 1 bouquet 6 heads artificial peony silk flower leaf home wedding party decor1
dhgate.com
2,727.60 руб.
256 leds 5000w grow light full spectrum led plant grow light indoor plant growing greenhouse garden lights
dhgate.com
4,778.88 руб.
Modern Art Minimalist Home Portable Closets Nonwovens Bedroom Furniture Free Assembly Multifunctional Foldable Wardrobe Closets
aliexpress.com
4,535.91 руб.
Six Corner Fire Flame Machine for engineering celebration wedding performance stage effect DMX512 hexagonal spray lighter 1pc
aliexpress.com
8,462.42 руб.
11.4V 4500Mah Lipo Battery For Fimi X8 Se Rc Quadcopter Spare Parts For Fimi X8 Se Rc Quadcopter Lipo Battery
aliexpress.com
3,905.79 руб.
350mm 500N 20mm/s Electric Linear Actuator Durable Window Door Opener Stroke Linear Motion Controller Quality
aliexpress.com
3,079.71 руб.
Kicute 80pcs Colors Painting Art Marker Pen Alcohol Marker Pen Cartoon Graffiti Double Headed Sketch Art Markers Set Black/White
aliexpress.com
784.66 руб.
Replcement Stubborn Dirt Brush Tool For Dyson V7 V8 SV10 SV11 Animal Absolute Vacuum Cleaner Parts Brushes Accessories
aliexpress.com
1,775.65 руб.
Snow Globe Santa Snowman Ball With Light Home Bedroom DIY Decoration Toys New Year Birthday Gifts Wind Up Toys
aliexpress.com
4,333.58 руб.
801 2.4G WIFI 720P Camera Mini Foldable Drone Altitude Hold Headless One-key Return 3D Eversion Speed Switch RC Quadcopter ht
aliexpress.com
2,995.27 руб.
OLEVS Romantic Lovers Quartz Watches Couple Women Men Waterproof Wristwatches Leather Bracelet Strap Gold Case Male Clock Watch
aliexpress.com
43.02 руб.
1 Set 4 Pin Female Tyco Amp 1-1813099-1 967325-1 1-1813099-2 AC Assembly Car Socket Waterproof Car Connector Oxygen Sensor Plug
aliexpress.ru
2,890.00 руб.
модные сандалии женские летние женские сандалии с открытым носком на толстой подошве новые римские сандалии сандалии на платформе с толстой подошвой на среднем каблуке плоские 40 белый
joom.ru
29,289.07 руб.
RocketRAID 2720/2710 SAS 6 ГБ RAID PCIe 2,0x8 карта перед отправкой идеальный тест
aliexpress.ru
638.00 руб.
Плюшевая косметичка Милая мягкая плюшевая пушистая косметичка Пушистая косметичка Портативная косметичка для розовый
joom.com
133.83 руб.
30 Pcs Culture Plate Tissue Equipment Science Experiment Lab Clear Specimen Container Petri Dish for Microscope Iced Supply
aliexpress.ru
249.34 руб.
Piano Cleaning and Maintenance Tools Cover Accessories Key Cloth for Keyboard Protector
aliexpress.ru
93.20 руб.
Durable 3.5mm 3.5 Jack 1 Male to 5 Female Earphone Splitter Audio Splitter Share Adapter Audio Cable Splitter
aliexpress.ru
325.81 руб.
Winter Puppy Sweatshirt Small to Medium Dog Thin Fleece Warm Hoodie with Leash Teddy Two-Leg Pullover
aliexpress.ru
2,280.00 руб.
Accordion Shoulder Belt Comfortable Accordion Harness Accordion Belt Fashionable Accordion Straps Suitable for Accordion синий
joom.com
5,135.00 руб.
Двухслойный футляр для очков с жестким корпусом двойного назначения, большой вместимости, противоударный, портативный футляр для контактных линз, дорожный чехол для хранения унисекс розовый
joom.com
1,326.00 руб.
Новые индивидуальные солнцезащитные очки в маленькой оправе, модные трансграничные мужские и женские очки в стиле ретро для женщин леопардовый/коричневый
joom.com







